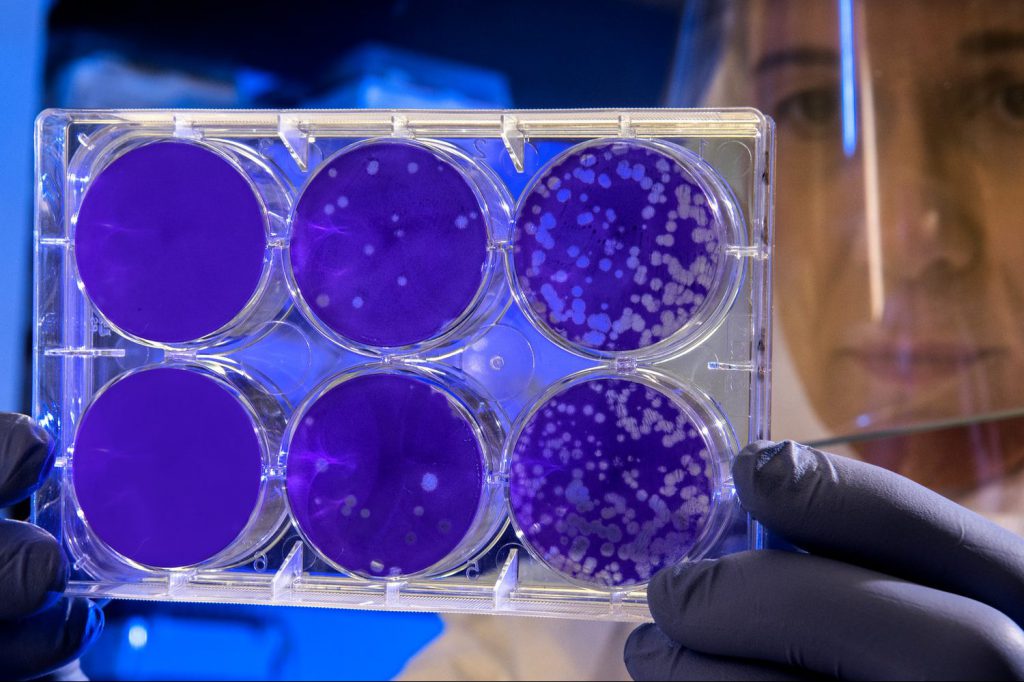

Bacterial Endocarditis
Bacterial endocarditis is an infection of the inner lining of the heart, often involving the heart valves.
It can develop in anyone, but is more likely to occur in people with pre-existing heart diagnoses, such as congenital heart conditions.
It’s important to be aware of things you can do to reduce the chance of these bacteria causing heart infections.

When someone has a bacterial infection it is usually possible to find out what type of bacteria are causing the infection by growing them in the lab from blood samples, as shown in the pictures. In people with bacterial endocarditis, the bacteria are often shown to be ones that live in our mouths or on our skin.
Bacterial endocarditis is rare, but if it does happen it can be very serious, even fatal. Most people will need to be in hospital for a minimum of 2 to 3 weeks having intravenous antibiotics, and in many cases people will need to stay in hospital for a total of 6 weeks.
Our mouths are full of bacteria that live in there. If our teeth and gums are healthy then the bacteria will usually stay in our mouths, but if our teeth and gums are unhealthy then the bacteria are more likely to get into our bloodstream and increase the risk of us developing bacterial endocarditis. Because of this it’s really important that you take good care of you teeth and gums
1
Make sure you look after your teeth!
Brush twice a day for 2 minutes.
Floss once a day.
2
Make sure you see your dentist and dental hygienist regularly.
Go at least once a year.
3
Some people should have antibiotics for dental work.
Talk to your cardiologist and your dentist.
Some people with congenital heart conditions are at particularly high risk of developing endocarditis. This includes people with replacement heart valves, people with cyanotic congenital heart disease (low oxygen levels), people who have had recent heart surgery or catheter intervention (within 6 months) and people who have had previous endocarditis.
In order to try to reduce the risk in this situation we recommend having antibiotics before some types of dental work and some surgical procedures. This recommendation has changed a bit in the last few years, so talk to your cardiologist if you are uncertain or you want to clarify this recommendation. Follow this link to the NZ Heart Foundation to get more information about endocarditis, or click here to download the NZ Heart Foundation wallet card.
Symptoms can include:
- An infection that lasts longer than everyday virus infections or is more severe than an everyday infection
- Feeling generally unwell with things like aches and pains, tiredness, decreased appetite or night sweats.
- A fever (a high temperature) develops at some stage in most cases.
If you develop symptoms like these or you are worried that you could have endocarditis, then get checked out quickly by your GP, or if you feel very unwell then go to the hospital emergency department. Endocarditis can be easier to treat if it is picked up early.

